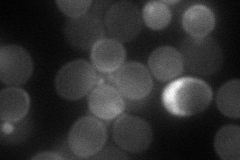
YNL293W
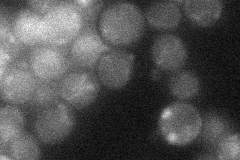
YNL293W
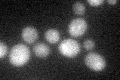
YNL293W

View description
GTPase-activating protein for Sec4p and several other Rab GTPases, regulates exocytosis via its action on Sec4p, also required for proper actin organization; similar to Msb4p; both Msb3p and Msb4p localize to sites of polarized growth
Localization:
Intensity:
Fold change:
Significance:
-
C’ GFP library in SD

below threshold17.66 -
N' NOP1pr-GFP in SD

cell periphery,bud neck54.2436 -
N' TEF2pr-mCherry in SD
cell periphery,bud neck56.5841 -
N' NATIVEpr-GFP in SD
below threshold21.1264 -
N' TEF2pr-VC and Cyto-VN in SD

bud neck37.4553 -
C’ GFP library in SD+DTT
cytosol17.650.99No -
C’ GFP library in SD+H2O2

cytosol19.171.08No -
C’ GFP library in Starvation Media

cytosol16.490.93No -
C’ GFP library on the background of Pup2-DaMP

below threshold -
C’ GFP library on the background of CCT mutant

below threshold18.39171.04123No
